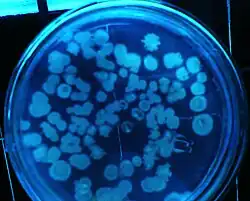

Antimicrobiano
| Plaguicidas | ||
|---|---|---|
| Pesticidas | ||
| ||
| Microbicidas y Antimicrobianos | ||
Un antimicrobiano es un agente que mata microorganismos o detiene su crecimiento.[1] Los medicamentos antimicrobianos se pueden agrupar de acuerdo con los microorganismos contra los que actúan principalmente. Por ejemplo, los antibióticos se usan contra las bacterias y los antifúngicos contra los hongos. También se pueden clasificar según su función. Los agentes que matan microbios se llaman microbicidas, mientras que los que simplemente inhiben su crecimiento se llaman biostáticos. El uso de medicamentos antimicrobianos para tratar la infección se conoce como quimioterapia antimicrobiana, mientras que el uso de medicamentos antimicrobianos para prevenir la infección se conoce como profilaxis antimicrobiana.
Las principales clases de agentes antimicrobianos son los desinfectantes ("antimicrobianos no selectivos", como el blanqueador), que matan una amplia gama de microbios en superficies no vivas para prevenir la propagación de enfermedades, antisépticos (que se aplican al tejido vivo y ayudan a reducir la infección durante cirugía) y antibióticos (que destruyen los microorganismos dentro del cuerpo). El término "antibiótico" originalmente describía solo aquellas formulaciones derivadas de microorganismos vivos, pero ahora también se aplica a los antimicrobianos sintéticos, como las sulfonamidas o fluoroquinolonas. El término también solía estar restringido a los antibacterianos (y los profesionales médicos y la literatura médica lo usan a menudo como sinónimo de ellos), pero su contexto se ha ampliado para incluir todos los antimicrobianos. Los agentes antibacterianos se pueden subdividir en agentes bactericidas, que matan las bacterias, y agentes bacteriostáticos, que ralentizan o detienen el crecimiento bacteriano. En respuesta, nuevos avances en tecnologías antimicrobianas han dado como resultado soluciones que pueden ir más allá de la simple inhibición del crecimiento microbiano. En cambio, se han desarrollado ciertos tipos de medios porosos para matar microbios en contacto.[2]
Historia
Se sabe que el uso de antimicrobianos ha sido una práctica común durante al menos 2000 años. Los antiguos egipcios y los antiguos griegos usaban mohos específicos y extractos de plantas para tratar la infección.[3]
En el siglo XIX, microbiólogos como Louis Pasteur y Jules Francois Joubert observaron el antagonismo entre algunas bacterias y discutieron los méritos de controlar estas interacciones en la medicina.[4] El trabajo de Louis Pasteur en fermentación y generación espontánea condujo a la distinción entre bacterias anaerobias y aerobias. La información obtenida por Pasteur llevó a Joseph Lister a incorporar métodos antisépticos, como esterilizar herramientas quirúrgicas y desbridar heridas en procedimientos quirúrgicos. La implementación de estas técnicas antisépticas redujo drásticamente el número de infecciones y muertes posteriores asociadas con procedimientos quirúrgicos. El trabajo de Louis Pasteur en el campo de los microbianos también condujo al desarrollo de muchas vacunas para enfermedades potencialmente mortales como el carbunco y la rabia. El 3 de septiembre de 1928, Alexander Fleming regresó de vacaciones y descubrió que una placa de Petri llena de Staphylococcus se separó en colonias debido al hongo antimicrobiano Penicillium rubens. Fleming y sus asociados lucharon por aislar el antimicrobiano, pero hicieron referencia a sus beneficios terapéuticos en el British Journal of Experimental Pathology de 1929.[5] En 1942, Howard Florey, Ernst Chain y Edward Abraham utilizaron el trabajo de Fleming para purificar y extraer la penicilina para usos medicinales, lo que les valió el Premio Nobel de Medicina de 1945.[6]
Químicos

Antibacterianos
Los antibacterianos se usan para tratar infecciones bacterianas. Los antibióticos se clasifican generalmente en betalactámicos, macrólidos, fluroquinolonas, tetraciclina o aminoglucósidos. Su clasificación dentro de estas categorías depende de sus espectros antimicrobianos, farmacodinámica y composición química. La toxicidad del fármaco para humanos y otros animales por antibacterianos generalmente se considera baja. El uso prolongado de ciertos antibacterianos puede disminuir el número de flora intestinal, lo que puede tener un impacto negativo en la salud. El consumo de probióticos y una alimentación razonable pueden ayudar a reemplazar la flora intestinal destruida. Los trasplantes de heces pueden considerarse para pacientes que tienen dificultades para recuperarse de un tratamiento prolongado con antibióticos, como para las infecciones recurrentes por Clostridium difficile.[7][8]
El descubrimiento, desarrollo y uso de antibacterianos durante el siglo XX ha reducido la mortalidad por infecciones bacterianas. La era de los antibióticos comenzó con la aplicación neumática de medicamentos de nitroglicerina, seguida de un período "dorado" de descubrimiento de aproximadamente 1945 a 1970, cuando se descubrieron y desarrollaron varios agentes estructuralmente diversos y altamente efectivos. Desde 1980, la introducción de nuevos agentes antimicrobianos para uso clínico ha disminuido, en parte debido al enorme gasto de desarrollar y probar nuevos medicamentos[9] Paralelamente, ha habido un aumento alarmante en la resistencia antimicrobiana de bacterias, hongos, parásitos y algunos virus a múltiples agentes existentes.[10]
Los antibacterianos se encuentran entre los medicamentos más utilizados y entre los medicamentos que los médicos usan habitualmente, por ejemplo, en infecciones virales del tracto respiratorio. Como consecuencia del uso generalizado y perjudicial de los antibacterianos, se ha producido una aparición acelerada de agentes patógenos resistentes a los antibióticos, lo que resulta en una grave amenaza para la salud pública mundial. El problema de la resistencia exige que se haga un esfuerzo renovado para buscar agentes antibacterianos eficaces contra las bacterias patógenas resistentes a los antibacterianos actuales. Las posibles estrategias para alcanzar este objetivo incluyen un mayor muestreo de diversos entornos y la aplicación de metagenómica para identificar compuestos bioactivos producidos por microorganismos actualmente desconocidos y no cultivados, así como el desarrollo de bibliotecas de moléculas pequeñas personalizadas para objetivos bacterianos.[11]
Antifúngicos
Los antifúngicos se usan para matar o prevenir un mayor crecimiento de hongos. En medicina, se usan como tratamiento para infecciones como el pie de atleta, la tiña y la candidiasis y funcionan explotando las diferencias entre las células de mamíferos y hongos. Matan el organismo fúngico sin efectos peligrosos en el huésped. A diferencia de las bacterias, tanto los hongos como los humanos son eucariotas. Por lo tanto, las células fúngicas y humanas son similares a nivel molecular, lo que hace que sea más difícil encontrar un objetivo para atacar un medicamento antimicótico que no existe también en el organismo infectado. En consecuencia, a menudo hay efectos secundarios a algunos de estos medicamentos. Algunos de estos efectos secundarios pueden poner en peligro la vida si el medicamento no se usa adecuadamente.
Además de su uso en medicina, con frecuencia se buscan antifúngicos para controlar el crecimiento de moho en materiales domésticos húmedos o mojados. El bicarbonato de sodio aplicado a las superficies actúa como un antifúngico. Otro suero antimicótico es una mezcla de peróxido de hidrógeno y un revestimiento de superficie delgada que neutraliza el moho y encapsula la superficie para evitar la liberación de esporas. Algunas pinturas también se fabrican con un agente antifúngico adicional para su uso en áreas de alta humedad, como baños o cocinas. Otros tratamientos de superficie antimicóticos típicamente contienen variantes de metales conocidos por suprimir el crecimiento de moho, por ejemplo, pigmentos o soluciones que contienen cobre, plata o zinc. Estas soluciones generalmente no están disponibles para el público en general debido a su toxicidad.
Antivirales
Los medicamentos antivirales son una clase de medicamentos utilizados específicamente para tratar infecciones virales. Al igual que los antibióticos, se usan antivirales específicos para virus específicos. Son relativamente inofensivos para el huésped y, por lo tanto, pueden usarse para tratar infecciones. Deben distinguirse de los viricidas, que desactivan activamente las partículas de virus fuera del cuerpo.
Muchos medicamentos antivirales están diseñados para tratar infecciones por retrovirus, principalmente VIH. Los medicamentos antirretrovirales importantes incluyen la clase de inhibidores de la proteasa. Los virus del herpes, mejor conocidos por causar herpes labial y herpes genital, generalmente se tratan con el análogo de nucleósido aciclovir. La hepatitis viral es causada por cinco virus hepatotrópicos (EA) no relacionados y puede tratarse con medicamentos antivirales dependiendo del tipo de infección. Los virus de la gripe A y B se han vuelto resistentes a los inhibidores de la neuraminidasa como el oseltamivir y la búsqueda de nuevas sustancias está activada.
Antiparasitarios
Los antiparasitarios son una clase de medicamentos indicados para el tratamiento de enfermedades infecciosas como la leishmaniasis, la malaria y la enfermedad de Chagas, que son causadas por parásitos como nematodos, cestodos, trematodos, protozoos infecciosos y amebas. Los medicamentos antiparasitarios incluyen metronidazol, yodoquinol y albendazol. Al igual que todos los antimicrobianos terapéuticos, deben matar al organismo infectante sin dañar gravemente al huésped.
No farmacéutico
Se utiliza una amplia gama de compuestos químicos y naturales como antimicrobianos. Los ácidos orgánicos se usan ampliamente como antimicrobianos en productos alimenticios, por ejemplo, ácido láctico, ácido cítrico, ácido acético y sus sales, ya sea como ingredientes o como desinfectantes. Por ejemplo, las carcasas de carne a menudo se rocían con ácidos, y luego se enjuagan o se cuecen al vapor, para reducir la prevalencia de E. coli.
Las superficies de aleación de cobre tienen propiedades antimicrobianas intrínsecas naturales y pueden matar microorganismos como E. coli, MRSA y Staphylococcus .[12] La Agencia de Protección Ambiental de los Estados Unidos ha aprobado el registro de 355 de tales aleaciones de cobre antibacterianas. Como medida de higiene pública, además de la limpieza regular, se están instalando aleaciones de cobre antimicrobianas en algunas instalaciones sanitarias y en sistemas de tránsito subterráneo. Otros cationes de metales pesados como Hg 2+ y Pb 2+ tienen actividades antimicrobianas, pero pueden ser tóxicos.
Los herbolarios tradicionales usaban plantas para tratar enfermedades infecciosas. Muchas de estas plantas han sido investigadas científicamente por su actividad antimicrobiana, y se ha demostrado que algunos productos vegetales inhiben el crecimiento de microorganismos patógenos. Varios de estos agentes parecen tener estructuras y modos de acción que son distintos de los de los antibióticos en uso actual, lo que sugiere que la resistencia cruzada con agentes que ya están en uso puede ser mínima.[13]
Aceites esenciales
Se afirma que muchos aceites esenciales incluidos en las farmacopeas herbales poseen actividad antimicrobiana, y los aceites de laurel, canela, clavo y tomillo son los más potentes en estudios con patógenos bacterianos transmitidos por los alimentos.[14][15] Los componentes activos incluyen productos químicos terpenoides y otros metabolitos secundarios . A pesar de su uso frecuente en la medicina alternativa, los aceites esenciales han tenido un uso limitado en la medicina convencional. Si bien del 25 al 50% de los compuestos farmacéuticos son derivados de plantas, ninguno se usa como antimicrobianos, aunque ha habido una mayor investigación en esta dirección.[16] Las barreras para un mayor uso en la medicina convencional incluyen una supervisión reguladora y un control de calidad deficientes, productos mal etiquetados o identificados erróneamente, y modos de entrega limitados.
Pesticidas antimicrobianos
Según la Agencia de Protección Ambiental de EE. UU. (EPA),[17] y definido por la Ley Federal de Insecticidas, Fungicidas y Rodenticidas, los pesticidas antimicrobianos se utilizan para controlar el crecimiento de microbios a través de la desinfección, el saneamiento o la reducción del desarrollo y para proteger objetos inanimados, procesos o sistemas industriales, superficies, agua u otras sustancias químicas por contaminación, ensuciamiento o deterioro causado por bacterias, virus, hongos, protozoos, algas o limo.
Productos pesticidas antimicrobianos
La EPA monitorea productos, como desinfectantes / desinfectantes para su uso en hospitales u hogares, con el fin de determinar la eficacia. Por lo tanto, los productos destinados a la salud pública se encuentran bajo este sistema de monitoreo, los que se usan para el agua potable, piscinas, saneamiento de alimentos y otras superficies ambientales. Estos productos pesticidas están registrados bajo la premisa de que, cuando se usan adecuadamente, no demuestran efectos secundarios irrazonables para los humanos o el medio ambiente. Incluso una vez que ciertos productos están en el mercado, la EPA continúa monitoreándolos y evaluándolos para asegurarse de que mantengan la eficacia en la protección de la salud pública.
Los productos de salud pública regulados por la EPA se dividen en tres categorías:[17]
- Esterilizadores (esporicidas): eliminarán todas las bacterias, hongos, esporas y virus.
- Desinfectantes: destruyen o inactivan microorganismos (bacterias, hongos, virus), pero pueden no actuar como esporicidas (ya que son la forma más difícil de destruir). Según los datos de eficacia, la EPA clasificará un desinfectante como limitado, general/amplio espectro, o como desinfectante hospitalario.
- Sanitizadores: reducen la cantidad de microorganismos, pero pueden no matarlos o eliminarlos a todos.
Seguridad de pesticidas antimicrobianos
Según un informe de 2010 de los CDC, los trabajadores de la salud pueden tomar medidas para mejorar sus medidas de seguridad contra la exposición a pesticidas antimicrobianos. Se aconseja a los trabajadores que minimicen la exposición a estos agentes usando equipo de protección, guantes y gafas de seguridad. Además, es importante seguir las instrucciones de manejo correctamente, ya que así es como la Agencia de Protección Ambiental lo ha considerado seguro. Se debe educar a los empleados sobre los riesgos para la salud y alentarlos a buscar atención médica en caso de exposición.[18]
Ozono
El ozono puede matar microorganismos en el aire, el agua y los equipos de proceso, como la ventilación de la cocina, cuartos de basura, trampas de grasa, plantas de biogás, moho y olores internos, plantas de tratamiento de aguas residuales, producción textil, cervecerías, lecherías, producción de alimentos e higiene, industrias farmacéuticas, plantas de embotellado, zoológicos, sistemas municipales de agua potable, piscinas y spas, y lavado de ropa.
Físicos
Calor
Tanto el calor seco como el húmedo son efectivos para eliminar la vida microbiana. Por ejemplo, los frascos utilizados para almacenar conservas como la mermelada se pueden esterilizar calentándolos en un horno convencional. El calor también se usa en la pasteurización, un método para frenar el deterioro de alimentos como la leche, el queso, los jugos, los vinos y el vinagre. Dichos productos se calientan a una temperatura determinada durante un período de tiempo establecido, lo que reduce en gran medida la cantidad de microorganismos nocivos.
Radiación
Los alimentos a menudo se irradian para matar los patógenos nocivos.[19] Las fuentes comunes de radiación utilizadas en la esterilización de alimentos incluyen cobalto-60 (un emisor gamma), haces de electrones y Rayos X.[20] La luz ultravioleta también se usa para desinfectar el agua potable, tanto en sistemas de uso personal a pequeña escala como en sistemas de purificación de agua comunitarios a gran escala.[21]
Véase también
Referencias
- ↑ «Antimicrobial». Merriam-Webster Online Dictionary. Archivado desde el original el 24 de abril de 2009. Consultado el 2 de mayo de 2009.
- ↑ «Antimicrobial Porous Media | Microbicidal Technology | Porex Barrier Technology». www.porex.com. Archivado desde el original el 3 de marzo de 2017. Consultado el 16 de febrero de 2017.
- ↑ M. Wainwright (1989). «Moulds in ancient and more recent medicine». Mycologist 3 (1): 21-23. doi:10.1016/S0269-915X(89)80010-2.
- ↑ Kingston W (June 2008). «Irish contributions to the origins of antibiotics». Irish Journal of Medical Science 177 (2): 87-92. PMID 18347757. doi:10.1007/s11845-008-0139-x.
- ↑ A. Fleming (1929). «On the Antibacterial Action of Cultures of a Penicillium, with Special Reference to their use in the Isolation of B. influenzae». The British Journal of Experimental Pathology 10 (3): 226-236.
- ↑ «The Nobel Prize in Physiology or Medicine 1945». The Nobel Prize Organization.
- ↑ Brandt LJ (Feb 2013). «American Journal of Gastroenterology Lecture: Intestinal microbiota and the role of fecal microbiota transplant (FMT) in treatment of C. difficile infection». Am J Gastroenterol 108 (2): 177-85. PMID 23318479. doi:10.1038/ajg.2012.450.
- ↑ Kellermayer R (15 de noviembre de 2013). «Prospects and challenges for intestinal microbiome therapy in pediatric gastrointestinal disorders». World J Gastrointest Pathophysiol 4 (4): 91-3. PMC 3829459. PMID 24244876. doi:10.4291/wjgp.v4.i4.91.
- ↑ Ventola C. L. (2015). «The Antibiotic Resistance Crisis, Part 1: Causes and Threats». Pharmacy and Therapeutics 40 (4): 277-283. PMC 4378521. PMID 25859123.
- ↑ «Multidrug resistance: an emerging crisis». Interdiscip Perspect Infect Dis 2014: 541340. 16 de julio de 2014. PMC 4124702. PMID 25140175. doi:10.1155/2014/541340.
- ↑ Committee on New Directions in the Study of Antimicrobial Therapeutics (2006). Challenges for the Development of New Antibiotics — Rethinking the Approaches. National Academies Press. NBK19843.
- ↑ «Copper Touch Surfaces». Archivado desde el original el 23 de julio de 2012. Consultado el 27 de septiembre de 2011.
- ↑ «The antifungal activity of Sarcococca saligna ethanol extract and its combination effect with fluconazole against different resistant Aspergillus species». Applied Biochemistry and Biotechnology 162 (1): 127-33. 2010. PMID 19685213. doi:10.1007/s12010-009-8737-2.
- ↑ A. Smith-Palmer; J. Stewart; L. Fyfe (1998). «Antimicrobial properties of plant essential oils and essences against five important food-borne pathogens». Letters in Applied Microbiology 26 (2): 118-122. PMID 9569693. doi:10.1046/j.1472-765x.1998.00303.x.
- ↑ «Antibacterial and antifungal properties of essential oils». Curr Med Chem 10 (10): 813-29. May 2003. PMID 12678685. doi:10.2174/0929867033457719.
- ↑ Cowan, Marjorie Murphy (1 de octubre de 1999). «Plant Products as Antimicrobial Agents». Clinical Microbiology Reviews 12 (4): 564-582. ISSN 0893-8512. PMC 88925. PMID 10515903. doi:10.1128/CMR.12.4.564.
- ↑ a b «Archived copy». Archivado desde el original el 20 de mayo de 2013. Consultado el 5 de mayo de 2013.
- ↑ Centers for Disease Control Prevention (CDC) (14 de mayo de 2010). «Acute antimicrobial pesticide-related illnesses among workers in health-care facilities – California, Louisiana, Michigan, and Texas, 2002–2007». MMWR Morb Mortal Wkly Rep 59 (18): 551-6. PMID 20467413.
- ↑ «20467413». US EPA. Consultado el 28 de octubre de 2014.
- ↑ «Irradiation of Food FAQ: What is the actual process of irradiation?». U.S. Centers for Disease Control and Prevention. Archivado desde el original el 20 de abril de 2016. Consultado el 17 de abril de 2016.
- ↑ «UV Disinfection Drinking Water». Water Research Center. Consultado el 18 de abril de 2016.
Enlaces externos
- El índice de antimicrobianos: una lista continuamente actualizada de agentes antimicrobianos encontrados en la literatura científica (incluye extractos de plantas y péptidos)
- Centro Nacional de Información sobre Pesticidas
- Descripción general del uso de antimicrobianos en aplicaciones plásticas
- CARGA de resistencia y enfermedad en las naciones europeas: un proyecto de la UE para estimar la carga financiera de la resistencia a los antibióticos en los hospitales europeos